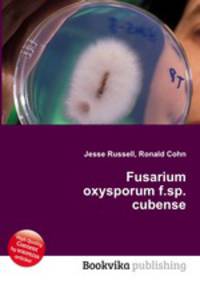
Fusarium oxysporum f.sp. cubense

Поиск книг, учебников, пособий в онлайн-магазинах
Fusarium oxysporum f.sp. cubense
Автор: Jesse Russell,Ronald Cohn, 102 стр., издатель: "Книга по Требованию", ISBN: 978-5-5138-3295-9High Quality Content by WIKIPEDIA articles! Fusarium oxysporum f.sp. cubense is a fungal plant pathogen that causes Panama disease of banana (Musa spp.), also known as fusarium wilt of banana. Данное издание представляет собой компиляцию сведений, находящихся в свободном доступе в среде Интернет в целом, и в информационном сетевом ресурсе "Википедия" в частности. Собранная по частотным запросам указанной тематики, данная компиляция построена по принципу подбора близких информационных ссылок, не имеет самостоятельного сюжета, не содержит никаких аналитических материалов, выводов, оценок морального, этического, политического, религиозного и мировоззренческого характера в отношении главной тематики, представляя собой исключительно фактологический материал.
Рейтинг книги: 


 4 из 5, 7 голос(-ов).
4 из 5, 7 голос(-ов).



 4 из 5, 7 голос(-ов).
4 из 5, 7 голос(-ов).




